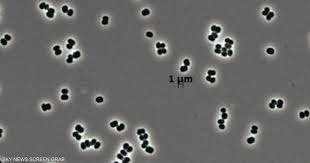

كشفت دراسة حديثة أن وكالة ناسا عثرت على نوع بكتيرى نادر يمتلك قدرة فريدة على الدخول في حالة خمول عميقة تجعله غير قابل للكشف تقريباً، ما يثير احتمالاً بأن يكون قد انتقل بالصدفة إلى المريخ على متن مركبات فضائية
اكتشاف بكتيريا فى أكثر الأماكن تعقيماً
البكتيريا الجديدة، التي أُطلق عليها Tersicoccus phoenicis، اكتُشفت قبل نحو عقد داخل غرف التعقيم الخاصة بتجميع المركبات الفضائية في ناسا ووكالة الفضاء الأوروبية، رغم أن هذه الغرف تُعدّ من أنظف البيئات على سطح الأرض
ورغم أنها غير مؤذية، أثارت قدرتها على النجاة في أقسى الظروف قلق العلماء بعد تكرار ظهورها في منشأتين تفصل بينهما آلاف الكيلومترات
كيف تتظاهر البكتيريا بالموت؟
أظهرت الدراسة أن البكتيريا قادرة على الدخول في سبات شبه كامل يمنع العلماء من رصدها أو تنميتها مخبرياً
يقول الباحث مادان تيرومالاي: “إنها لا تموت.. كانت فقط تتظاهر بالموت”، كما تحمل جيناً يسمح لها بإعادة تنشيط نفسها عند توفر ظروف معينة، ما يمكّنها من البقاء مختبئة لفترات طويلة
تهديد محتمل لاستكشاف الفضاء والصناعات المعقمة
فتح ظهور هذه البكتيريا الباب أمام احتمالات وصول ميكروبات مشابهة إلى مركبات فضائية متجهة إلى المريخ أو أماكن أخرى رغم البروتوكولات الصارمة
ويشير الباحثون إلى أن المشكلة تمتد إلى الصناعات الدوائية والزراعية والمستشفيات، حيث يمكن لميكروبات “مختبئة” أن تفلت من الفحوصات التقليدية
لماذا يثير هذا الاكتشاف القلق؟
يمكن للبكتيريا البقاء خاملة حتى بعد تزويدها بالمواد الغذائية
قد تعود للحياة عند ملامستها بكتيريا أخرى تفرز بروتينات معيّنة
تستطيع العيش لسنوات في بيئات جافة ومعقمة تماماً
ضعف الدفاعات المناعية للبشر في الفضاء قد يجعلها أكثر خطورة على رواد الفضاء
ويرى العلماء أن احتمال نجاة هذه البكتيريا في الفضاء ضعيف لكنه غير مستبعد، ما يستدعي تشديد الرقابة على غرف تصنيع المركبات الفضائية واستخدام تقنيات جديدة للبحث عن الميكروبات “النائمة”
وكالات










